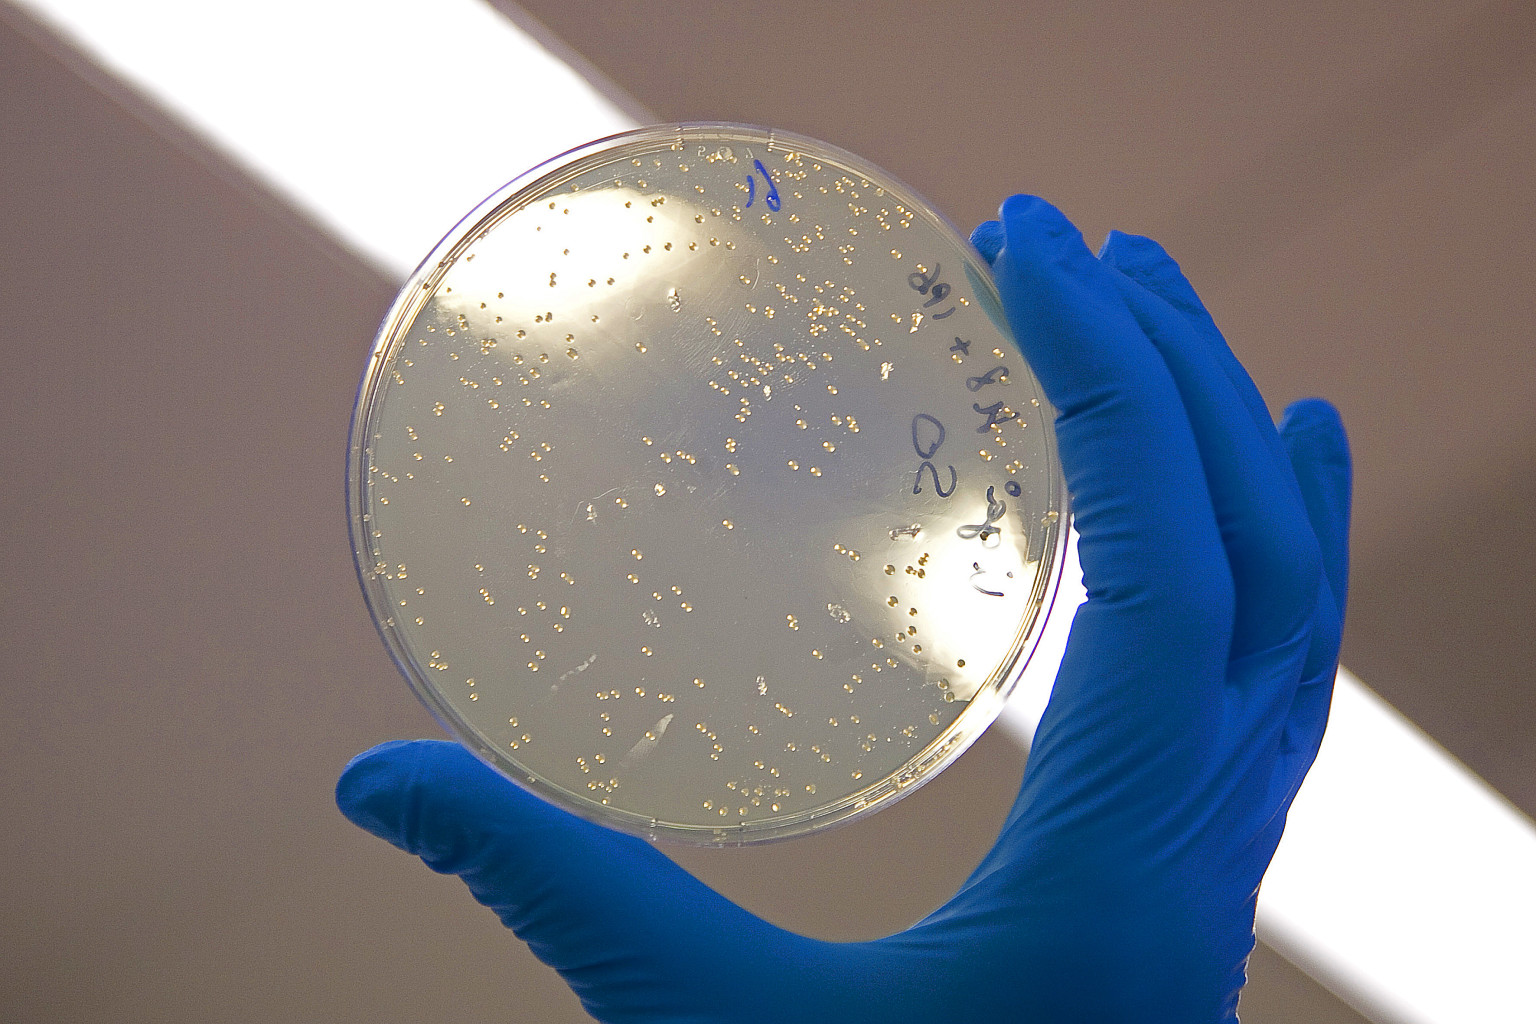

Un coup de théâtre, mais surtout une annonce passionnante, dans le monde de la recherche contre le cancer. Le groupe français Cellectis a révélé ...
Cellectis
Plus de 10 % de hausse vendredi pour l'action Celyad (ex-Cardio3 BioSciences), ce qui marque sa plus forte progression intraday depuis le 25 août...
L’action Cellectis rebondissait vendredi pour la troisième séance d’affilée, gagnant 1,44 % à 31,62 euros sur Euronext Paris (mais plus fortement...
La ruée vers les CAR-T se poursuit avec un deal qui valorise plus de 8 milliards de dollars Juno Therapeutics, une société d’une centaine de pers...
Cellectis a progressé de 38 % il y a 3 semaines, suite à des rumeurs de marché, véhiculées par le Financial Times, faisant état d’une négociation...
L’action-reflet Cellectis grimpait de 16 % jeudi en fin de séance sur le Nasdaq américain à 47,66 dollars, à la suite d’un article du Financial T...
L'ADS Cellectis a terminé en repli de 5,30 % mercredi à 39,30 dollars pour sa première séance de cotations à Wall Street. Le mouvement baissier n...
Les investisseurs américains, à qui s’adressait exclusivement l’opération, n’ont pas boudé les actions-reflet (ADS) Cellectis. Le pionnier de l’i...
Cellectis a déposé mardi une nouvelle version de son document d'enregistrement (le formulaire F-1) auprès du gendarme boursier américain. Ce nouv...
L’entreprise française Cellectis spécialisée de l’ingénierie du génome, qui développe des traitements contre le cancer fondés sur des cellules CA...